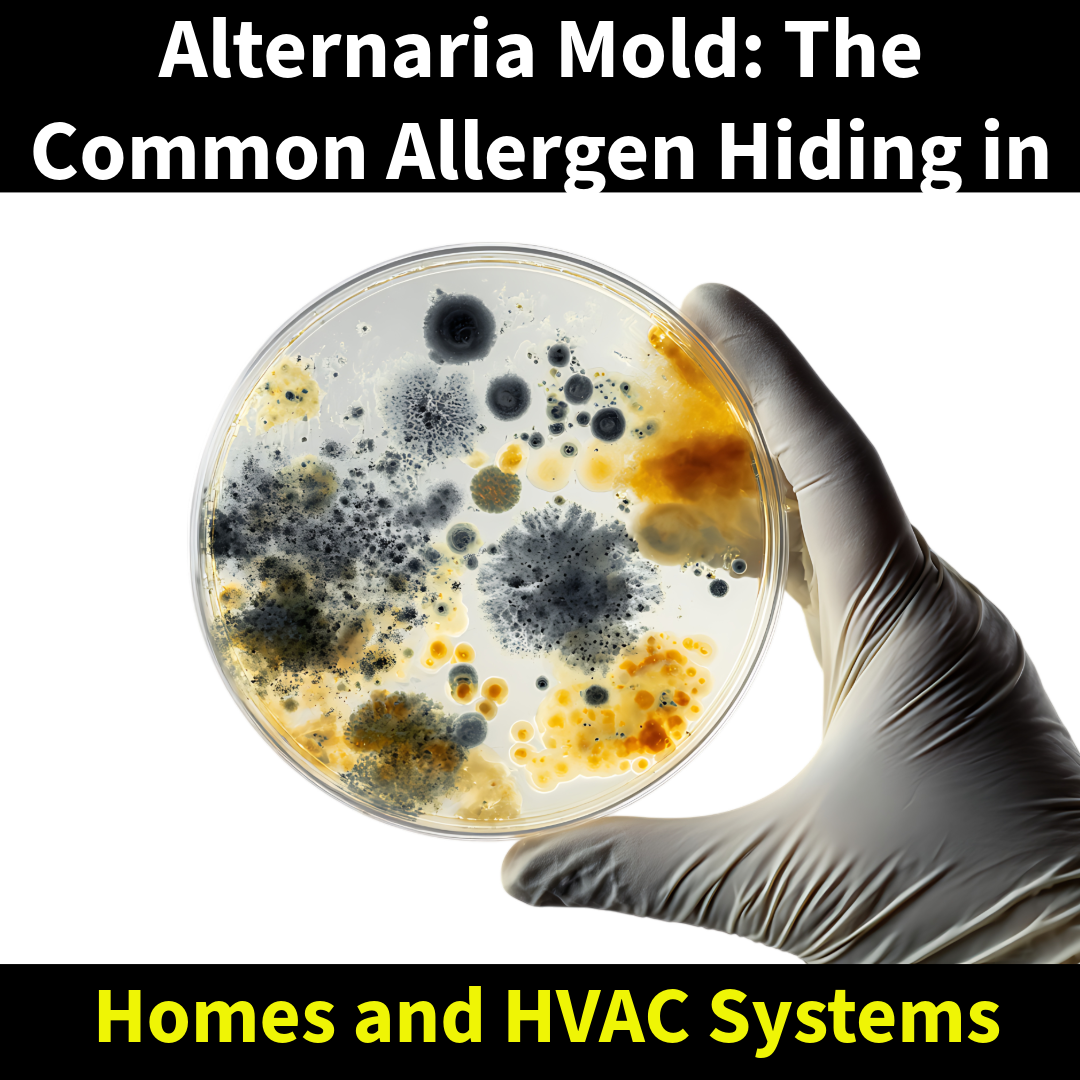

Our
Response Time
24 Hour Emergency Service
After you have scheduled your remediation service with us, this is what you can expect on the day we arrive.
Alternaria (pronounced al-ter-NAIR-ee-uh) is one of the most common molds found in both indoor and outdoor environments. Often...

Hoarding doesn’t just create clutter — it can drastically reduce a property’s value and complicate any attempt to...

When water enters your home — whether from a leak, burst pipe, or storm — time becomes the...